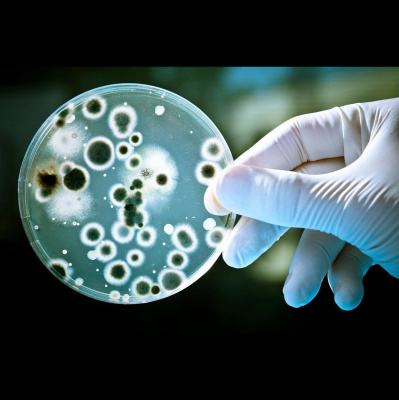
60-second Science

60-second Science
Microbes Share Your Morning Metro Commute
- Author: Vários
- Narrator: Vários
- Publisher: Podcast
- Duration: 0:02:58
- More information
Informações:
Synopsis
An analysis of the Hong Kong metro found microbes, including some with antibiotic resistance genes, freshly disperse throughout the system each day. Christopher Intagliata reports. Learn more about your ad choices. Visit megaphone.fm/adchoices